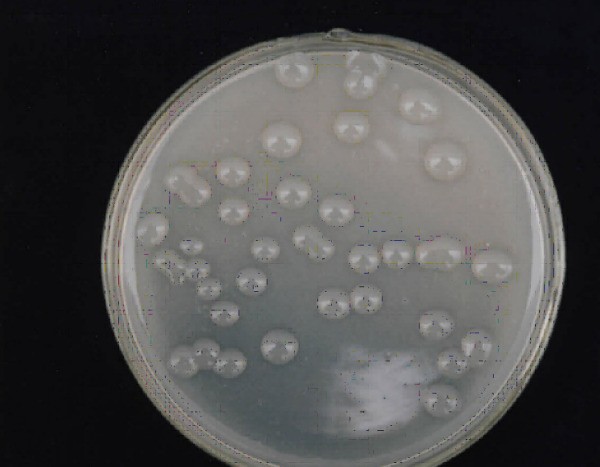

薄荷的组织培养基的配制方法较为复杂。通常情况下,薄荷组织培养基的配制需要考虑多个因素,包括植物生长激素、离子平衡、营养成分等。以下是一个简单的薄荷组织培养基配制步骤:
1. 选择合适的植物生长激素:薄荷组织培养通常会使用2,4-D(2,4-二甲基苯氧基甲烷)和NAA(硝酸盐氮)等植物生长激素。这些激素可以在实验室中购买到。
2. 确定离子平衡:不同的植物对离子平衡的要求不同,对于薄荷来说,合适的离子平衡是关键。通常情况下,使用含有大量硝酸盐和硫酸盐(N2O4)的培养基可以维持良好的离子平衡。
3. 添加营养成分:除了激素和离子平衡外,还需要添加其他营养成分以支持植物正常生长。例如,将甘露醇与蔗糖混合使用可以提供足够的能量和水分,并且有助于促进细胞分裂和生长。
4. 配制母液:将植物生长激素、离子平衡和营养成分分别配制成母液,以便在实验过程中使用。这些母液通常需要保存在冰箱中以稳定其活性。
5. 稀释培养基:将所需的母液按照比例混合在一起,形成最终的薄荷组织培养基。通常情况下,使用0.1-0.2%的甘露醇和0.2-0.4%的硝酸盐来配制培养基。
6. 添加铁盐单独:铁元素对于植物的生长和发育非常重要,因此在薄荷组织培养基中单独添加铁盐可以提供足够的铁元素。
7. 不添加其他有机除草剂:除草剂对于薄荷的正常生长并不必要,因此在薄荷组织培养基中不需要添加其他有机除草剂。
总结起来,薄荷组织培养基的配制需要考虑多个因素,并且需要遵循特定的步骤。只有正确配制出合适的薄荷组织培养基才能保证植物正常生长和发育。
1. 选择合适的植物生长激素:薄荷组织培养通常会使用2,4-D(2,4-二甲基苯氧基甲烷)和NAA(硝酸盐氮)等植物生长激素。这些激素可以在实验室中购买到。
2. 确定离子平衡:不同的植物对离子平衡的要求不同,对于薄荷来说,合适的离子平衡是关键。通常情况下,使用含有大量硝酸盐和硫酸盐(N2O4)的培养基可以维持良好的离子平衡。
3. 添加营养成分:除了激素和离子平衡外,还需要添加其他营养成分以支持植物正常生长。例如,将甘露醇与蔗糖混合使用可以提供足够的能量和水分,并且有助于促进细胞分裂和生长。
4. 配制母液:将植物生长激素、离子平衡和营养成分分别配制成母液,以便在实验过程中使用。这些母液通常需要保存在冰箱中以稳定其活性。
5. 稀释培养基:将所需的母液按照比例混合在一起,形成最终的薄荷组织培养基。通常情况下,使用0.1-0.2%的甘露醇和0.2-0.4%的硝酸盐来配制培养基。
6. 添加铁盐单独:铁元素对于植物的生长和发育非常重要,因此在薄荷组织培养基中单独添加铁盐可以提供足够的铁元素。
7. 不添加其他有机除草剂:除草剂对于薄荷的正常生长并不必要,因此在薄荷组织培养基中不需要添加其他有机除草剂。
总结起来,薄荷组织培养基的配制需要考虑多个因素,并且需要遵循特定的步骤。只有正确配制出合适的薄荷组织培养基才能保证植物正常生长和发育。